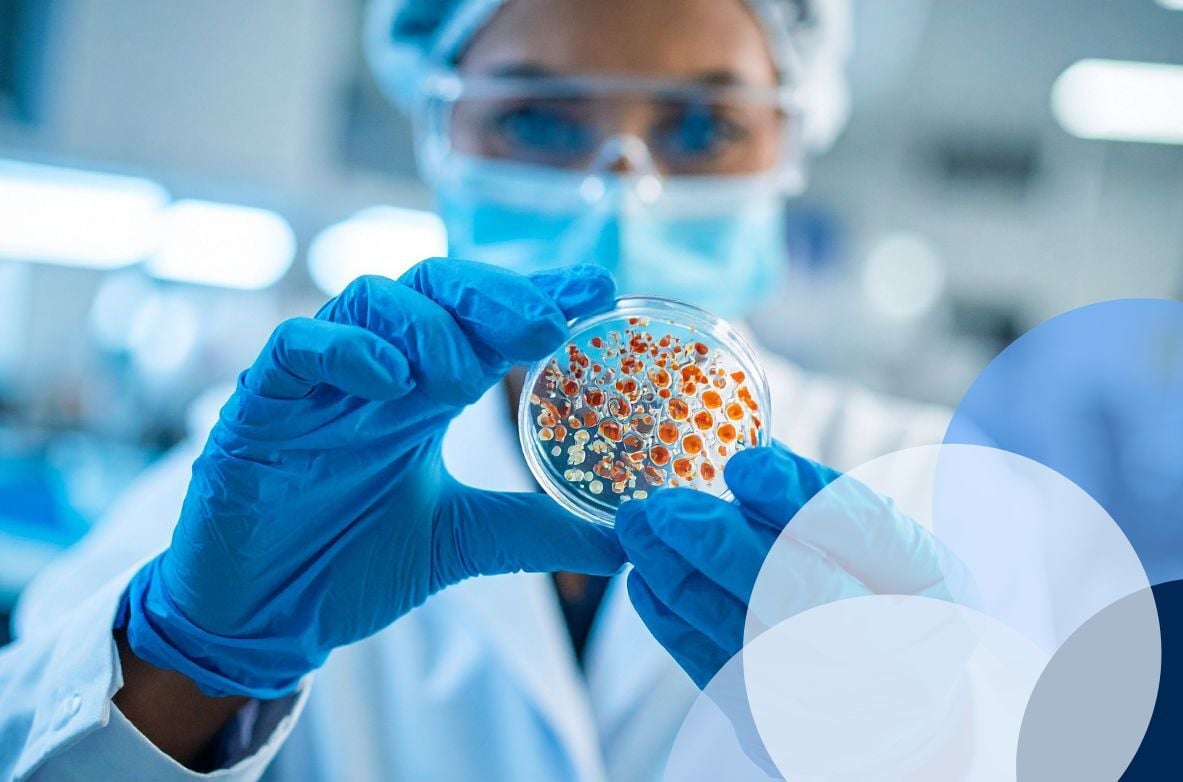
Emerging Biotech Solutions - CTA

Decidir si una estrategia de designación huérfana se adapta a un programa de desarrollo requiere más que evaluar los incentivos principales. Las diferencias en las definiciones regulatorias, los umbrales de evidencia, los plazos, la exclusividad y los incentivos entre regiones pueden influir materialmente tanto en la planificación del desarrollo como en el valor comercial a largo plazo. Para los equipos de biotecnología en etapas tempranas, estas consideraciones deben formar parte de la toma de decisiones estratégicas tempranas, y no ser un ejercicio regulatorio tardío.
Las definiciones regulatorias dan forma a la viabilidad
La elegibilidad para la designación huérfana no se define de manera uniforme en todas las regiones. En la UE y el Reino Unido, la designación depende no solo de la rareza, sino también de la gravedad de la enfermedad. La afección debe ser mortal o gravemente incapacitante y afectar a no más de 5 de cada 10 000 personas.
En EE. UU., el estado de huérfano se basa principalmente en la prevalencia, centrándose en afecciones que afectan a menos de 200 000 pacientes a nivel nacional, con una vía alternativa en la que es poco probable que se recuperen los costos de desarrollo.
Para los programas globales, esto significa que un producto puede calificar claramente como huérfano en EE. UU., mientras que requiere un caso más sólido y cuidadosamente justificado en Europa y el Reino Unido que aborde la epidemiología, la carga de la enfermedad y la necesidad médica no cubierta en paralelo.
Las terapias existentes elevan el nivel de evidencia
La presencia de terapias autorizadas afecta directamente el posicionamiento huérfano, particularmente en Europa. En la UE y el Reino Unido, si ya existen métodos satisfactorios de diagnóstico, prevención o tratamiento, la designación de huérfano solo puede otorgarse si el producto demuestra un beneficio significativo, como una ventaja clínicamente relevante o una contribución importante a la atención del paciente.
Este concepto se encuentra en el núcleo del marco europeo de medicamentos huérfanos y tiene implicaciones prácticas para las primeras opciones de desarrollo, incluida la selección de puntos finales, la estrategia de comparación y el posicionamiento clínico general. En EE. UU., la designación de huérfano no se basa en una evaluación de beneficio significativo estructurada equivalente en la etapa de designación, lo que resulta en una dinámica regulatoria diferente incluso cuando el contexto clínico parece similar.
El momento importa y difiere según la región
El calendario es una variable estratégica crítica. En la UE, la designación de huérfano puede solicitarse en cualquier momento antes de la presentación de la solicitud de autorización de comercialización, incluidas las etapas tempranas de desarrollo, siempre que se disponga de justificación suficiente.
Es importante destacar que los criterios de huérfano no solo deben cumplirse en la designación, sino que también deben mantenerse y reevaluarse en el momento de la aprobación para asegurar la exclusividad. Por lo tanto, la designación temprana representa un compromiso estratégico a largo plazo en lugar de un único hito regulatorio.
En EE. UU., la designación de huérfano puede solicitarse de manera similar en cualquier momento antes de la presentación de la NDA o BLA, incluso durante el desarrollo preclínico o clínico temprano. El Reino Unido sigue un modelo diferente.
No existe un procedimiento de designación de huérfano temprano independiente, y el estado de huérfano se evalúa como parte del propio proceso de autorización de comercialización. Como resultado, la estrategia de designación huérfana del Reino Unido está inherentemente vinculada a la solidez, consistencia y madurez del dossier completo, en lugar de a una decisión de designación anterior.
Las diferencias de exclusividad afectan la planificación del ciclo de vida
Las disposiciones de exclusividad de mercado influyen aún más en la planificación estratégica. En la UE, la designación de huérfano puede conferir 10 años de exclusividad de mercado posterior a la aprobación, con posibles extensiones vinculadas a obligaciones pediátricas.
El Reino Unido ofrece de manera similar hasta 10 años de exclusividad, aunque esto puede reducirse en circunstancias específicas. Por el contrario, EE. UU. ofrece siete años de exclusividad para la indicación huérfana aprobada.
Estas diferencias pueden afectar significativamente la gestión del ciclo de vida, las indicaciones de seguimiento y la secuencia de lanzamiento geográfico, y deben tenerse en cuenta en las decisiones comerciales, clínicas y de inversión tempranas.
Los incentivos son reales pero no equivalentes
El valor tangible de la designación de huérfano varía según la región. En la UE, el estado de huérfano proporciona acceso a incentivos regulatorios como reducciones de tarifas para la Asistencia de Protocolo y otras interacciones regulatorias, lo que influye directamente en los costos de desarrollo y la estrategia de participación de la agencia.
En EE. UU., el marco de designación de huérfano está más orientado financieramente, ofreciendo incentivos como créditos fiscales para ensayos clínicos calificados y exenciones de ciertas tarifas de usuario de la FDA. El Reino Unido ofrece sus propios incentivos y reembolsos de tarifas, pero estos difieren en alcance y estructura de los disponibles en la UE.
Como resultado, el momento en que la designación de huérfano ofrece un valor significativo y cómo ese valor apoya el desarrollo depende en gran medida de la región.
Una decisión estratégica con impacto a largo plazo
En conjunto, estas diferencias refuerzan una conclusión clave. Decidir temprano si una estrategia de designación huérfana es adecuada es una decisión estratégica del desarrollador, no meramente regulatoria.
Las definiciones, las expectativas de evidencia, las limitaciones de tiempo, los períodos de exclusividad y los incentivos difieren en la UE, EE. UU. y el Reino Unido, y cada uno puede dar forma al diseño del desarrollo, la exposición al riesgo, las prioridades de inversión y el valor del programa a largo plazo.
Los equipos que evalúan estas dimensiones tempranamente están mejor posicionados para construir una estrategia de designación huérfana coherente y globalmente alineada que apoye el éxito regulatorio al tiempo que permite un desarrollo sostenible y una toma de decisiones informada.
¿Necesitas apoyo para definir tu estrategia huérfana a tiempo?
QbD Group apoya a los equipos de biotecnología en la traducción del potencial científico en una estrategia de designación huérfana lista para la regulación y globalmente coherente, desde el posicionamiento temprano y la planificación de la designación hasta la generación de evidencia y la optimización del ciclo de vida.
Habla con nuestros expertos en regulación y desarrollo para reducir los riesgos de tu camino.
Mantente a la vanguardia en Life Sciences
Mantenerte al día con la vertiginosa industria de las Life Sciences no tiene por qué ser abrumador.
Nuestro boletín te ofrece las últimas novedades, actualizaciones de la industria y contenido de expertos directamente en tu bandeja de entrada, ayudándote a mantenerte informado y tomar decisiones más inteligentes.
Sobre el autor
PhD · Global Head Regulatory Affairs at QbD Group
Angeles has built her career at the crossroads of science and regulation. From academic research at CNB and CNIC to leadership roles in biotech and global consulting firms like Asphalion, Parexel, Pharmalex, and Scendea, she translates regulatory complexity into action. She has a strong track record of building and scaling teams, and is especially focused on the intersection of data, AI, and regulation to unlock faster healthcare innovation.
QbD Group
¿Necesita ayuda con los procesos regulatorios? Nuestros expertos pueden guiarle.
Solicitar asesoría experta →


